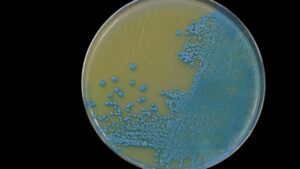
李斯特菌

01
足吃足玩+演出电影,费城华埠夏日欢庆活动就在今天下午!
一到暑假,费城唐人街就人人人从从从众众众。今天(7月20日)下午,随着费城华埠夏日欢庆活动拉开帷幕,费城唐人街的人气将更加火爆。

图片来源:pcdc
这个夏日欢庆活动,包括牌楼旁边的主舞台,一向北延伸的工艺品摊位和在位于礼士街(Race St.)的美食摊位.购物、演出、文化体验全都有,丰富多彩。

为了让孩子们也能享受夏日时光,欢庆活动还为小朋友准备了蹦床、面部彩绘等多种亲子娱乐活动。主体活动从下午1点到7点举行,露天电影从晚上8点开始放映。来吧,我在费城唐人街等你!
02
包括宾州,全美12州已有20多人患病,2人死亡,致命李斯特菌正在爆发中
美国疾病控制和预防中心(CDC)发布了一项关于涉及到美国12个州的李斯特菌(Listeria)爆发警告。据报道,此次感染与熟食店柜台出售的切片肉类有关。
图片来源:cbs
根据美国疾病控制与预防中心的数据,疫情已导致28人住院,2人死亡。其中,纽约州目前报告的感染人数最多,有7例。死亡的两人中,1人在伊利诺伊州,1人在新泽西州。CDC绘制的一张疫情地图上显示,宾州目前有1个病例,新泽西州有2例,特拉华州没有病例。
据报道,李斯特菌很容易在熟食店的设备、台面、手和食物中传播。这种细菌会导致严重疾病,包括发烧、肌肉酸痛、头痛、脖子僵硬、意识模糊、失去平衡和抽搐。
CDC建议孕妇、老年人和免疫系统较弱的人避免吃熟食柜台切开出售的熟肉,因为这些群体感染李斯特菌重症的风险更高。从熟食柜台买来的熟肉最好加热到内部温度73℃,并在热气腾腾时食用。
03
注意新骗局!骗子利用短信和钓鱼网站套取用户通行费

图片来源:whyy
据报道,这个“钓鱼”短信假冒宾州收费公路委员会,通知短信接收人没有支付通行费,并威胁说如果不及时支付费用,将收取额外费用。短信中,还会附上一个假冒的宾州收费公路官方网站链接,引导大家完成支付。
宾州收费公路委员会(PTC)有关负责人表示,自上周六(7月13日)PTC首次收到骗局举报以来,他们已经收到了3000多份报告。
该负责人同时表示,骗子是随机向手机用户发信息,PTC不存在数据泄露的问题。他提醒大家,PTC永远不会通过短信直接与用户沟通。
04
富国银行中心将在下周一举办招聘会,300多个兼职岗位等你来!
位于南费城的富国银行中心(Wells Fargo Center)将在下周一上午9点至下午3点30分举办一场招聘会。
在此次招聘会上,富国银行中心将释放出300多个兼职职位,以填补该场馆运营、安保、客户服务和零售等各个部门的空缺。

图片来源:cbs
说话富国银行中心常年举行各种比赛和演出,是费城大热的休闲娱乐场所。如果你正好想找一份兼职工作,又正好喜欢热闹,那在富国银行中心工作真的是不二之选,赶快安排上吧!
登录网址查看招聘会更多信息:
www.wellsfargocenterphilly.com/events/detail/hiring-event-7-22
05
美版“萝卜快跑”来了?肯尼迪机场上线自动驾驶摆渡车

图片来源: fox
据报道,这款无人驾驶摆渡车载有一个卫星接收器和六个传感器,使用“光增强现实”(Light-AR)技术,让摆渡车知道自己的路径,并可以在有东西靠近时减速或停车。
目前,有两辆无人驾驶摆渡车参加试点。在接下来的两个月里,该试点项目从周一至周五上午8点到中午12点提供服务。
不过,原来的摆渡车司机并没有失业,他们将在无人驾驶汽车上确保行驶安全,并最终实现远程监控摆渡车的目标。




